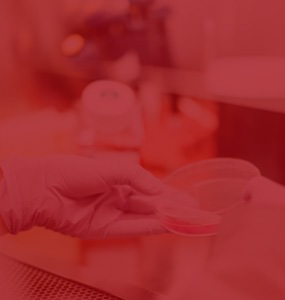

出行便利

福利待遇

完善医疗制度
匈牙利投资移民
预计即将在3月开放申请






教育
匈牙利是一个拥有高水平教育的国家,实行12年制义务教育。匈牙利的高等教育是世界闻名的,尤其在医学、经济和技术方面有卓著的成就
医疗
全体公民人人受保,即不分城镇或乡村,每月需缴纳25欧元费用即可受保,他们的所有家庭成员,包括子女老人也享受同等待遇。

育儿福利
匈牙利有3种不同的育儿补助,用于补贴那些愿意在家照看儿童的母亲的收入。国家每月至少会补助母亲产前工资的70%。

经济
匈牙利经济的多元化结构使其更具韧性和竞争力。工业制造业、农业产业和旅游业的相互支持和平衡发展,为匈牙利提供了可持续的经济增长动力。

宜居
匈牙利全境以平原为主,80%的国土海拔不足200米,属多瑙河中游平原。全年日照时间为2038小时,南方的日照时间较多。年平均风速为2.2米/秒,年平均降水量约为630毫米。


在
线
咨
询
投资移民
购房移民
技术移民
海外身份
留学申请
职业测评
背景提升
教育规划
精品房源
学区房
银行开户
税务保险

